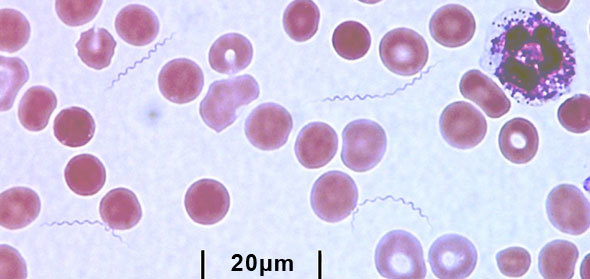

Zoonoses
Infectious diseases of other animal species that are accidentally transmitted to humans.
May be viral, bacterial or parasitic.
Vector
Arthropod that transmits infection from animal to human.
Not all zoonoses are transmitted by vectors.
Reservoir
The animal species in which the microbe is maintained in nature.
Lyme Disease
B. burgdorferi
Morphology and Cultivation

B. burgdorferi
Reservoirs
Zoonotic disease w/ animal and tick reservoir.
White footed mouse ⇒ larval and nymph forms (spring)
White tailed deer ⇒ adult ticks (late summer)
Infection of humans (accidental)

B. burgdorferi
Transmission
Spirochetes transmitted by ticks that normally feed on deer and white footed mouse:

B. burgdorferi
Epidemiology
Transmission occurs in areas with a large deer population.
Three distinct geographic regions in the US:
B. burgdorferi
Clinical Infection
3 stages of Lyme disease:

B. burgdorferi
Pathogenesis
Pathology not due to the organism ⇒ no toxins or direct tissue damage
B. burgdorferi
Diagnosis

B. burgdorferi
Treatment
Post-Treatment
Lyme Disease Syndrome
Chronic Lyme Disease
Persistent pain, fatigue, cognitive sx in the absence of clinical and serological e/o infection w/ B. bergdorferi
Not recognized by the IDSA
B. burgdorferi
Prevention
Cover all exposed skin areas and/or use repellent when in tick infected areas
Check for ticks and remove daily

Relapsing Fever
Overview

Epidemic
Relapsing Fever
Louse Borne Relapsing Fever

Endemic
Relapsing Fever
Tick Borne Relapsing Fever
Relapsing Fever
Virulence Factors
Relapsing Fever
Pathogenesis and Clinical Disease

Relapsing Fever
Diagnosis
Relapsing Fever
Treatment and Prevention